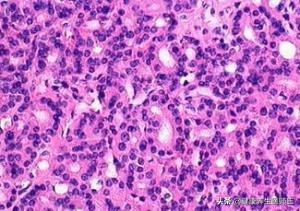
生命缘生殖细胞肿瘤案例,上皮内瘤变是癌变吗

外阴上皮内瘤变
确诊依据活组织病检,主要镜下病理特征为上皮层内细胞异型性及核分裂象增加。
病灶切除是主要的治疗方式,年轻、病灶局限的普通型患者可采用局部药物和物理治疗。

外阴上皮内瘤变是一组外阴病变的病理学诊断名称,包括外阴鳞状上皮内瘤变和外阴非鳞状上皮内瘤变(Paget病和非浸润性黑色素瘤),多见于45岁左右的妇女,近年外阴上皮内瘤变发生率有所增加。
1、 病因
不完全清楚,目前认为大多数与人乳头瘤病毒(HPV)16型感染有关,也可能与外阴性传播疾病或肛门--生殖道病变、免疫抑制以及吸烟相关。
2、 病理
上皮内瘤变的病理特征为上皮层内细胞分化不良、核异常及核分裂象增加。病变始于基底层,严重时向上扩展甚至占上皮全层。过去根据外阴上皮内瘤变细胞分化不良、核异常核分裂象以及在上发层病变程度,将外阴上皮内瘤变分为1一III级,但随着对外阴上皮内瘤变病程认识的深人,2004年国际外阴疾病研会对外阴上皮内瘤变定义分类进行了修正,认为外阴上皮内瘤变 I型主要是HPV感染的反应性改变,外阴上皮内瘤变仅指高级别外阴上皮内瘤变(II---III)。
分类见表外阴上皮内瘤样病变分类及特征
分类 大体观 镜下观
普通型 皮肤病损界限清晰
(与HPV感染有关)
疣型 呈湿疣样外观 见挖空细胞,角化不全及角化过度细胞,上皮棘层肥厚,细胞异型明显
基底细胞型 呈扁平样增生改变 挖空细胞少于疣型,上皮层增厚,内见
或非乳头瘤病变 呈基底细胞样未分化细胞从基底向上扩展
混合型 兼有上述两种类型的表现
(与IPV感染无关)
分化型 局部隆起、溃疡,疣状丘疹 细胞分化好,细胞异型限于上皮基
或过度角化 底层,基底细胞角化不良,表皮网脊,内常有角化蛋白形成
未分化型 其他不能归入普通型或分化型,如Paget,其病理特征为基底层见大而不规则的圆形、卵圆形或多边形胞,细胞质空面透亮,核大小、形态、染色不一(Paget细胞),表皮基底膜完整

三、临床表现
1、症状 主要为外阴瘙痒、皮肤破损、烧灼感及溃疡等。
2、体征 病灶可发生在外阴任何部位,可见外阴丘疹,斑点,斑块或乳头状赘疣,单个或多个,融合或分散,灰白或粉红色;少数为略高出皮面的色素沉着。
四、诊断利别诊断
确诊依据活体组织病理检查,对任何可疑病变应作多点活检。取材时应注意深度,避免遗漏浸润癌, 阴道镜检查或采用1%甲苯胺蓝或3%-5%醋酸涂抹外阴病变皮肤,有助于提高病灶活检的准确率。
外阴湿疹、外阴白色病变、痣、脂溢性角化瘤和黑色棘皮瘤等也可引起,注意与这些疾病鉴别,以及这些疾病与外阴上皮内瘤变并存的情况。
5、 治疗
治疗的目的在于消除病灶,缓解症状和预防恶变。治疗应根据患者年龄、病变大小及分类,恶变风险、对外阴形态及功能影响等选择个体化方案。治疗前应做活组织检查以明确诊断和排除早期浸润癌。
1. 局部治疗 适应于病灶局限、年轻的普通型患者。可采用:
①药物治疗:5%氟尿嘧啶软膏等外阴病灶涂抹和局部免疫反应调节剂咪喹莫特;
②物理治疗:可用激光、冷冻、电灼以及光动力学治疗,特别是*光汽激**化的效果更佳。
2、 手术治疗 手术方式依据病变范围、分类和年龄来决定。
①对局限的分化型病灶可采用外阴上皮局部表浅切除术,切除边缘超过肿物外缘0.5-1.0cm即可;
②对大的病变可行表浅外阴切除术(外阴皮肤剥除)和薄层皮片植皮术;
③老年人和广泛性外阴上皮内瘤变,特别是分化型患者采用单纯外阴切除,切除范围包括外阴皮肤及部分皮下组织,但不切除会阴筋膜;对Paget病,由于病变多超越肉眼所见病灶边缘,且偶有浸润发生,应行较广泛局部病灶切除或单纯外阴切除:若出现浸润或合并汗腺癌时,需做广泛性外阴切除和双侧腹股沟淋巴结切除术。